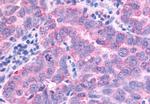
PAK7 Antibody in Immunohistochemistry (Paraffin) (IHC (P))
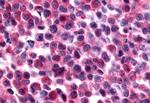
PAK7 Antibody in Immunohistochemistry (Paraffin) (IHC (P))

Search
Invitrogen
PAK7 Polyclonal Antibody
{{$productOrderCtrl.translations['antibody.pdp.commerceCard.promotion.promotions']}}
{{$productOrderCtrl.translations['antibody.pdp.commerceCard.promotion.viewpromo']}}
{{$productOrderCtrl.translations['antibody.pdp.commerceCard.promotion.promocode']}}: {{promo.promoCode}} {{promo.promoTitle}} {{promo.promoDescription}}. {{$productOrderCtrl.translations['antibody.pdp.commerceCard.promotion.learnmore']}}
产品信息
PA5-34102
种属反应
宿主/亚型
分类
类型
抗原
偶联物
形式
浓度
规格
纯化类型
保存液
内含物
保存条件
运输条件
RRID
产品详细信息
Percent identity with other species by BLAST analysis: Human, Gorilla (100%) Orangutan, Gibbon, Monkey (95%) Marmoset (90%).
靶标信息
PAK7 (KIAA1264) is implicated in the regulation of cytoskeletal dynamics, proliferation, and cell survival signaling. This kinase contains a CDC42/Rac1 interactive binding motif, and has been shown to bind CDC42 in the presence of GTP. This kinase is predominantly expressed in brain. It is capable of promoting neurite outgrowth, and thus may play a role in neurite development. This kinase is associated with microtubule networks and induces microtubule stabilization. The subcellular localization of this kinase is tightly regulated during cell cycle progression. Alternatively spliced transcript variants encoding the same protein have been described.
仅用于科研。不用于诊断过程。未经明确授权不得转售。
篇参考文献 (0)
生物信息学
蛋白别名: p21 (RAC1) activated kinase 7; p21 protein (Cdc42/Rac)-activated kinase 7; p21(CDKN1A)-activated kinase 7; p21-activated kinase 5; p21-activated kinase 7; p21CDKN1A-activated kinase 7; PAK 5; PAK 7; PAK-5; PAK-7; PAK5; protein kinase PAK5; RP5-1119D9.3; Serine/threonine-protein kinase PAK 5; serine/threonine-protein kinase PAK 7; serine/threonine-protein kinase PAK7; unnamed protein product
基因别名: KIAA1264; PAK5; PAK7
UniProt ID: (Human) Q9P286
Entrez Gene ID: (Human) 57144